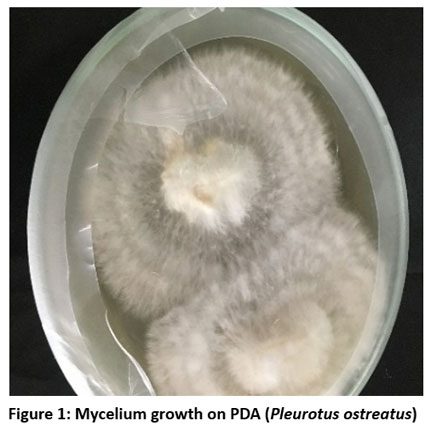

Introduction
Mushrooms are the fungi; they can be appeared either below or above the ground. About 12,000 species of mushroom are available around the world of which approximately 2000 are fit to eat and have applications in medicines and around 35 are commercially cultivated.1 According to their applications, mushrooms can be categorised into 3 main groups, 54 percent are edible mushrooms, 38 percent have medicinal properties and 8 percent are available in wild.2 Some mushrooms are reported to have medicinal properties while some are toxic.3 Mushrooms are providing economic to human. Since ages, collection and gathering of mushrooms is being undergoing by the local people. Mushrooms are consumed for their great nutrition. Mushrooms are also utilized for medicines. They have high nutritional value and their therapeutic potential are well-established.4,5 Some mushrooms are nutraceuticals.6,7 Mushrooms possess great nutritional value, they are rich in protein, minerals, vitamins, fiber and have very less or no calories & cholesterol.8-11 Valuable bioactive compounds are present in mushrooms and they have antioxidant activity.11 Mushrooms are reported possess antiviral, antifungal, antibacterial, antiparasitic, antiinflammatory, anticoagulant, antioxidant, antiproliferative, cytotoxic, antidiabetic, antitumor, anticancer and contain hypocholesterolaemia and hepatoprotective compounds.12-14 The level of mushrooms consumption is increasing because of the nutritional benefits and palatability. More progress can be made for mushrooms in the field of food as well as in the areas of medicine and unemployment also. The cultivation and consumption of mushrooms are increasing day by day because of their nutritional and health benefits. Edible mushrooms are nutritive, flavorful and also have medicinal properties.15
Many mushrooms belong to the oyster mushrooms.16 Firstly, oyster mushroom was described in 1775.17 Paul Kummer, the German mycologist transferred the Oyster mushroom in the year 1871 to the genus Pleurotus.17 Pleurotus ostreatus is a macro fungus belongs to the Family Pleurotaceae of the phylum Basidiomycota. It is being cultivated for long in Asia, China and Japan.18 The other species of oyster mushroom include P. ostreatus, P. sajor-Caju, P. cystidiosus, P. tuber-region, P. flabellate, P. pulmonarias, P. citrinopileatus, P. florida, P. sapidus, P. eryngii, P. tuberregium.17 Pleurotus ostreatus are reported to have low calories and fat. Pleurotus ostreatus is reported to be edible, nutritious and is commercially cultivated for its nutritional and medicinal importance.19 Pleurotus ostreatus is good source of proteins, amino acid, minerals, fiber, vitamins, carbohydrates, and lipids, and. Pleurotus ostreatus is can be the source of vitamin B1, B2, B3, B9 and ascorbic acid and it can help in reducing the cholesterol level in experimental animals.17 In another report, Pleurotus ostreatus was found to contain vitamin A, vitamin C, vitamin D and vitamin B1, B2 & B6, Folic acid, Niacin and Pantothenic acid.19 Pleurotus ostreatus is reported to be helped in lowering blood pressure, supporting the immune system, building strong bones, regulating cholesterol levels, protecting from neurodegenerative diseases and cardiovascular disease.20 Therefore, Pleurotus ostreatus are being cultivated for food and for utilizing in the production other value-added products. Setting up standard protocol for the tissue culture and cultivation of Pleurotus ostreatus are needed. Considering the importance of Pleurotus ostreatus, in the present study, the development of mycelium of Pleurotus ostreatus by tissue culture on PDA medium, spawn production using rice grain and cultivation of Pleurotus ostreatus on straw substrate was performed successfully.
Materials and Methods
Oyster mushroom, Pleurotus ostreatus was collected from the local cultivation of Manipur. Tissue culture, spawn production and cultivation of Pleurotus ostreatus were performed in the Institutional Biotech Hub Laboratory of Dept. of Biotechnology, S. Kula Women’s College, Nambol, Bishnupur, Manipur, India.
Tissue culture and Cultivation
Mycelium production
In vitro culture of Pleurotus ostreatus were performed. Potato dextrose agar (PDA) was used for the first inoculation of the mushroom. For Potato dextrose agar medium 200 gram of potato, dextrose 2.0%, 15-gram agar in 1 litre of distilled water. PDA was sterilized at a temperature of 121°C and 15 psi pressure for 20 to 30 minutes. Cap tissue of the Pleurotus ostreatus was taken as the sample for in vitro tissue culture for mycelium production. On the PDA, the sample tissues were inoculated and kept in the incubator maintain a temperature of 26˚C. Mycelium was observed to be seen in few days after inoculation. After 7-15 days from the day of inoculation, the mycelium was sub-cultured on PDA again.
Spawn production
Rice grain was washed thoroughly with tap water and soaked overnight. The soaked rice grain was then boiled in water. The boiled grain was air dried and after that the grain was treated with calcium carbonate and calcium sulphate. The treated rice grain was packed in polypropylene bags and sterilization was done at 121°C and 15 psi pressure for 90 to 120 minutes. The sterilized grain was inoculated with the Pleurotus ostreatus mycelium and kept in the incubator at 26˚C.
Cultivation on rice straw substrate
The mycelium was inoculated on the sterilized rice grain and incubated at 26˚C. After 20-25 days, the spawn was taken for cultivation in rice straw substrate. Rice straw was chopped into a length of around 3-5 cm and treated with formaldehyde and carbendazim and left air dried. The straw was packed in polytene bags and spawn was laid in layer. Treatment of the straw with formaldehyde at a concentration of 100 ml per 100 liters of water and carbendazim 10 gram per 100 liters of water are often used to create a clean and favorable environment of the mushroom growth. This sterilization step reduces contamination and enhances faster colonization of mycelium on the substrate.
Results and Discussion
Mycelium growth was observed on the Potato dextrose agar (PDA) starting from 6 – 21 days (Fig. 1). After 7 to 15 days from the day of inoculation, the mycelium was sub-cultured on PDA again. For the spawn production, rice grain was soaked and then boiled in water and air dried. In the treated and sterilized grain inoculation of the mycelium from the PDA were performed and after few days’ mycelium was seen spreading in the treated rice grain. Complete running of the spawn was observed in 20 – 25 days and they were taken for cultivation on the straw substrate. After full colonization of the mycelium on the substrate, Pin head was observed in 25-35 days and few days later, they started to mature and the full-grown mushroom was harvested.
The results of the present study showed that oyster mushroom, Pleurotus ostreatus was observed to show mycelium growth on the PDA successfully and rice grain was used for developing the spawn. Thus, the study indicates that PDA and rice grain can be used for mass culture and consequently spawn production of Pleurotus ostreatus. In addition, the substrate used during the study was rice straw, full running of mycelium was observed in the rice straw substrate and thus, rice straw can be used as substrate for mass cultivation of Pleurotus ostreatus. Pleurotus ostreatus are used as food and in production various value-added products. It has good nutritive and medicinal values. Therefore, cultivation of Pleurotus ostreatus can be a great income source.
In the present study, dextrose was used as the carbon source. Memon et al.,21 cultured mushroom and studied the effect of different concentrations of carbon source using dextrose sugar were reported. Dextrose is reported to be the best carbon source on the culture of P. ostreatus and P. florida.22 The growth of mycelium of Pleurotus ostreatus on PDA medium was also successful during the study and finally gave a good harvest after cultivation. Many researchers also reported potato dextrose agar media was used during the culturing of Oyster mushrooms. Many other also reported tissue culture study of Pleurotus ostreatus.22,23 The mycelial growth of Pleurotus ostreatus was observed to be 1.5 cm within 2 days on PDA media supplemented with 20 gram of dextrose sugar.22 In a study by Neelam et al.,23 Pleurotus florida and Pleurotus ostreatus were cultured and they reported that was the best carbon source was found to be dextrose. Krupodorova et al.24 also reported the tissue culture of Pleurotus ostreatus tissue culture.
The growing and production of Pleurotus ostreatus are simple and are less expensive. Tissue culture is the simple method; media compositions and the growth regulator play important role in the culture of mushroom mycelium and can produce mycelial culture. Mycelium growth by tissue culture technique and production of spawn are the starting steps for mushrooms cultivation. Media culture and fungal mycelia growth are the two important parts of tissue culture of mushrooms. They can be cultivated by purchasing spawn from the market or they can be grown starting from their tissue culture. Media culture and fungal mycelia growth are the two important parts of tissue culture of mushrooms. Furthermore, many studies can be undertaken to study the effect of hormones on the growth of mycelium which will put more insight in mushroom cultivation.
|
Figure 1: Mycelium growth on PDA (Pleurotus ostreatus)Click here to view Figure |
Conclusion
PDA medium was used for the tissue culture of Pleurotus ostreatus, spawn development was done on treated rice grain and cultivated on straw substrate. Thus, this procedure can be adopted for the cultivation of Pleurotus ostreatus for a good harvest.
Acknowledgement
The authors would like to thank the Advanced Level Institutional Biotech Hub Laboratory, Department of Biotechnology, S. Kula Women’s College, Nambol, Bishnupur, Manipur, India.
Funding Sources
The author profoundly grateful to the Department of Biotechnology, New Delhi, GOI (No. BT/NER/143/ SP44482/2021) for financial assistance for conducting the experiment.
Conflict of Interest
The authors do not have any conflict of interest.
Data Availability Statement
This statement does not apply to this article.
Ethics Statement
This research did not involve human participants, animal subjects, or any material that requires ethical approval.
Informed Consent Statement
This study did not involve human participants, and therefore, informed consent was not required.
Author Contributions:
Wahengbam Robindro Singh: Funding Acquisition, Resources, Supervision
Romesh Sagolshemcha: Visualization, Supervision, Project Administration.
Thokchom Pusparani Devi: Performing the experiment, Writing – Original Draft.
Ibemhal Devi Asem: Conceptualization, Methodology, Analysis, Writing – Review & Editing.
References
- Beulah G.H., Margret A.A. & Nelson J. Marvelous Medicinal Mushrooms. J. Pharm. Biol. Sci; 2013; 3: 611-615.
- Royse D.J., Baars J. & Tan Q. Current overview of mushroom production in the world. In Edible and Medicinal Mushrooms: Technology and Applications; Zied DC, Pardo-Giminez A, Eds.; John Wiley & Sons Ltd.: Hoboken, NJ, USA; 2017; pp. 5–13. ISBN 978-1-119-14941-5.
CrossRef - Mowsurni, F. R., & Chowdhury, M. B. K. Oyster mushroom: Biochemical and medicinal prospects. Bangladesh Journal of Medical Biochemistry; 2010; 3(1), 23-28.
CrossRef - Vaz J.A., Barros L., Martins A., Morais J.S., Vasconcelos M.H. & Ferreira I.C. Phenolic profile of seventeen Portuguese wild mushrooms. LWT Food Sci. Technol; 2011; 44: 343-346.
CrossRef - Vaz J.A., Barros L., Martins A., Morais J.S., Vasconcelos M.H. & Ferreira I.C. Chemical composition of wild edible mushrooms and antioxidant properties of their water soluble polysaccharidic and ethanolic fractions. Food Chem; 2011; 126: 610-616.
CrossRef - Elmastas M., Isildak O., Turkekul I. & Temur N. Determination of antioxidant activity and antioxidant compounds in wild edible mushrooms. Food Comp Anal; 2007; 20: 337-345.
CrossRef - Ribeiro B., Valentao P., Baptista P., Seabra R.M. & Andrade P.B. Phenolic compounds, organic acids profiles and antioxidative properties of beefsteak fungus (Fistulina hepatica). Food Chem Toxicol; 2007; 45: 1805-1813.
CrossRef - Manzi, P., Gambelli, L., Marconi, S., Vivanti, V., & Pizzoferrato, L. (1999). Nutrients in edible mushrooms: an inter-species comparative study. Food chemistry, 65(4), 477-482.
CrossRef - Agrahar-Murugkar, D., & Subbulakshmi, G. J. F. C. (2005). Nutritional value of edible wild mushrooms collected from the Khasi hills of Meghalaya. Food Chemistry, 89(4), 599-603.
CrossRef - Wani, B. A., Bodha, R. H., & Wani, A. H. (2010). Nutritional and medicinal importance of mushrooms. Journal of Medicinal plants research, 4(24), 2598-2604.
CrossRef - Sharma, S. K., & Gautam, N. (2017). Chemical and bioactive profiling, and biological activities of coral fungi from northwestern Himalayas. Scientific reports, 7(1), 46570.
CrossRef - Ajith, T. A., & Janardhanan, K. K. (2007). Recent Advances in Indian Herbal Drug ResearchGuest Editor: Thomas Paul Asir DevasagayamIndian Medicinal Mushrooms as a Source of Antioxidant and Antitumor Agents. Journal of Clinical Biochemistry and Nutrition, 40(3), 157-162.
CrossRef - Lindequist, U., Niedermeyer, T. H., & Jülich, W. D. (2005). The pharmacological potential of mushrooms. Evidence‐Based Complementary and Alternative Medicine, 2(3), 285-299.
CrossRef - Wasser, S. P., & Weis, A. L. (1999). Medicinal properties of substances occurring in higher basidiomycetes mushrooms: current perspectives. International Journal of medicinal mushrooms, 1(1).
CrossRef - Assemie A., & Abaya G. The effect of edible mushroom on health and their biochemistry. International journal of microbiology; 2022; (1), 8744788.
CrossRef - Zięba P., Sękara A., Sułkowska-Ziaja K., & Muszyńska B. (2020). Culinary and medicinal mushrooms: Insight into growing technologies. Acta Mycologica; 2020; 55(2).
CrossRef - Kadam P., Yadav K., Karanje A., Giram D., Mukadam R., & Patil M. The food and medicinal benefits of oyster mushroom (Pleurotus ostreatus): a review. International Pharmaceutical Science & Research; 2023;14(2): 883-890.
- Ikon M., Udobre E. A., Etang U. E., Ekanemesang U. M., Ebana R. U., & Edet U. O. Phytochemical screening, proximate composition and antibacterial activity of oyster mushroom, Pleurotus ostreatus collected from Etim Ekpo in Akwa Ibom state, Nigeria. Asian Food Science Journal; 2018; 6(2): 1-10.
CrossRef - Igile G. O., Bassey S. O., Ekpe O. O., Essien N. M., & Assim-Ita E. Nutrient composition of oyster mushroom (Pleurotus ostreatus), grown on rubber wood sawdust in Calabar, Nigeria, and the nutrient variability between harvest times. European Journal of Food Science and Technology; 2020;8: 46-61.
- Mowsurni, F. R., & Chowdhury, M. B. K. Oyster mushroom: Biochemical and medicinal prospects. Bangladesh Journal of Medical Biochemistry, (2010); 3(1), 23-28.
CrossRef - Memon A. A., Mangrio G. S., Kaleri A. A., Kumar B., Khan M., Kaleri R. R., … & Wahocho N. A. Effect of dextrose sugar on the growth and production of oyster mushroom (Pleurotus ostreatus) through tissue culture. Journal of Basic & Applied Sciences; 2017; 13: 139-142.
CrossRef - Thulasi E. P., Thomas P. D., Ravichandran B., & Madhusudhanan, K. Mycelial culture and spawn production of two oyster mushrooms, Pleurotus florida and Pleurotus eous on different substrates. J. Biol. Technol; 2010; 1(3): 39-42.
- Neelam, Chennupati S., & Singh S. Comparative studies on growth parameters and physio-chemical analysis of Pleurotus ostreatus and Pleurotus florida. Asian Journal of Plant Science & Research; 2013, 3(1):163-169
- Krupodorova, T., Barshteyn, V., Tsygankova, V., Sevindik, M., & Blume, Y. Strain-specific features of Pleurotus ostreatus growth in vitro and some of its biological activities. BMC biotechnology; 2024; 24(1), 9.
CrossRef

